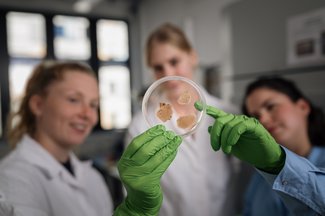

Career | Education
CeMESS is driven by the people who lead its teaching, research, and administration. Recruitment and training form the foundation of the Centre’s progress and success.
A key focus at CeMESS is the active support of talented postdoctoral researchers, alongside the training and development of exceptional PhD students. Through the Vienna Doctoral School in Microbiology and Environmental Science, early-career researchers benefit from outstanding supervision and access to state-of-the-art infrastructure, enabling them to advance their scientific careers.
The Centre’s unique research focus serves as the foundation for teaching that reflects the latest advancements in the field. CeMESS members are not only dedicated researchers but also passionate educators, contributing to a wide range of undergraduate and graduate courses.